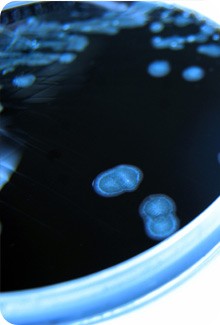

Campylobacter jejuni
While the food we eat in Canada is among the safest in the world, sometimes it may carry bacteria that can make us sick, like Campylobacter jejuni.
What is Campylobacter jejuni?
Campylobacter jejuni (C. jejuni) bacteria are found naturally in the intestines of poultry, cattle, swine, rodents, wild birds and household pets like cats and dogs. The bacteria have also been found in untreated surface water (caused by fecal matter in the environment) and manure.
C. jejuni is the most common type of campylobacter bacteria involved in human illness. People who eat food contaminated by C. jejuni bacteria can become ill with campylobacteriosis. Like other foodborne illnesses, the symptoms of campylobacteriosis can feel like stomach flu, but they can also develop into serious illness with long-lasting effects.
How do people get sick?
Both animals and people can be carriers of C. jejuni bacteria. They can then spread the bacteria to foods, surfaces, other animals or people. Food and beverages can become contaminated when handled by an infected person, or from cross-contamination when raw foods or pets are handled improperly.
The most common way of getting campylobacteriosis is by eating contaminated foods. Common sources of C. jejuni bacteria include:
- raw or undercooked meat like poultry, beef, pork and lamb
- raw milk and other raw dairy products
- raw vegetables
- shellfish
- untreated drinking water
Exposure to C. jejuni bacteria is also associated with the development of:
- Guillain-Barré syndrome (an auto-immune disorder affecting the nervous system)
- Reactive arthritis (a condition that develops in response to an infection in another part of the body and can lend to chronic arthritis)
- Irritable bowel syndrome (IBS)
- Infections of specific parts of the body (bloodstream, septicemia, appendix, gall bladder, central nervous system, colon, heart, urinary tract, abdominal cavity)
What are the symptoms and treatment?
Did you know?
Intestinal illness can be caused by viruses, bacteria or parasites, and usually involves vomiting and diarrhea. People often call it the flu, though it is in no way related to the influenza virus, which causes respiratory illness.
People infected with C. jejuni bacteria can experience a wide range of symptoms. Some do not get sick at all, though they can still spread the infection to others. Others feel as though they have a bad case of the flu. A rare few become seriously ill and must be hospitalized.
Most people with campylobacteriosis develop the following symptoms two to five days after being infected (though symptoms can appear as late as one month after infection):
- diarrhea (often bloody or watery)
- abdominal pain
- fever
- nausea
- vomiting (sometimes)
Fast fact
Campylobacteriosis affects children under five and young adults (15-29) more frequently than other age groups.
The illness can last up to ten days, and most people recover without treatment. As with any disease causing diarrhea or vomiting, people infected should drink plenty of liquids to replace lost body fluids and prevent dehydration. Although anyone can get campylobacteriosis, pregnant women, people with weakened immune systems, young children and older adults are most at risk for developing serious complications.
While long-term consequences are rare, a small number of people may get the following illnesses:
- septicemia (an infection of the bloodstream)
- sudden gall bladder inflammation (which can feel like a sharp abdominal pain)
- Guillain-Barré syndrome (an auto-immune disorder affecting the nervous system)
- meningitis (inflammation of the brain and spinal cord)
- Reiter's syndrome (a condition that develops in response to an infection in another part of the body and can lead to chronic arthritis)
- chronic colitis (inflammation of the colon)
How do I avoid getting sick?
Food safety tip
When cooking a chicken or turkey, it is safest to cook the stuffing in a separate dish, to prevent cross-contamination and undercooking. For more on cooking poultry safely, see Poultry Safety.
Foods contaminated with C. jejuni look, smell and taste normal. The good news is, C. jejuni and many other harmful bacteria can be killed by cooking food properly.
These tips will help protect you and your family from C. jejuni:
- Cook food to a safe internal temperature using a digital thermometer.
- Poultry and meat should be well cooked, not pink in the middle. If you are served undercooked food in a restaurant, send it back.
- Buy shellfish from reputable suppliers.
- Drink water from a safe (treated or boiled) water supply.
- Only buy clean and uncracked eggs. Store eggs in their original carton (so you can check the "best before" date) and place them in the coldest section of the fridge, not the door.
- Eat and drink only pasteurized juice, cider, milk and milk products. Mother's milk is the safest food for infants.
- When buying and storing groceries, keep raw meats separate from fruits, vegetables, cooked foods and ready-to-eat foods.
- Wash your hands before handling any food. Be sure to wash your hands, cutting boards, counters, knives and other utensils after preparing raw foods.
- Wash raw fruits and vegetables thoroughly with clean, safe running water before you prepare and eat them. Use a brush to scrub produce with firm or rough surfaces, like oranges, cantaloupes, potatoes and carrots.
- Never place cooked food on the unwashed plate that held raw meat, poultry or fish. Wash thermometers in between testing.
- Keep pets away from food storage and preparation areas. Wash your hands well with soap and water after handling pet treats, pet food and pet toys, or after playing with or cleaning up after your pet.
- If you have been diagnosed with campylobacteriosis or any other gastrointestinal illness, do not prepare food or pour water for other people.
- If you are diagnosed with campylobacteriosis, be sure that you or your doctor tells the local Public Health Department. If many cases happen at the same time, it may mean that a restaurant or a particular food item has a problem that needs to be corrected.
Also, these safe food practices will reduce your risk of contracting campylobacteriosis and other foodborne illnesses.
Food safety tip
Pasteurization destroys C. jejuni and other harmful bacteria. Try using pasteurized egg products when preparing foods that traditionally contain raw eggs, like eggnog, mayonnaise, salad dressing, ice cream and mousses.
What does the Government do to protect me?
In Canada, several government organizations work together every day to keep your food safe:
- Health Canada makes food safety standards and policies to help minimize the risk of foodborne illnesses.
- The Canadian Food Inspection Agency (CFIA) enforces these policies and standards and carries out inspections to make sure the food industry meets its food safety responsibilities. The CFIA works with Health Canada to make sure that foodborne illness is detected early and warnings go out to the public quickly.
- We are carrying out a five-year Food and Consumer Safety Action Plan, to strengthen and modernize Canada's safety system and make sure you can have confidence in the quality and safety of the food, health and consumer products you buy.
- We are investing $75 million more in Canada's food safety system (on top of the $113 million committed in 2008) to hire more inspectors, update lab technology, and improve communication with Canadians.
- We support and participate in public awareness campaigns about safe food practices, like the Canadian Partnership for Consumer Food Safety Education's Be Food Safe program, which encourages Canadian consumers to think of food safety at every step of the food handling process, from shopping for groceries to re-heating leftovers.
Page details
- Date modified: